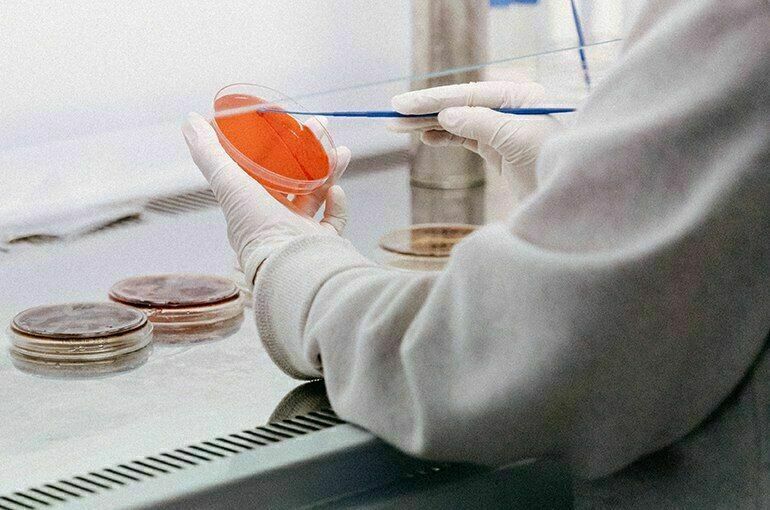

В Роспотребнадзоре исключили попадание в Россию чумы из Монголии
Но регионам рекомендовали повысить у медиков настороженность к этой болезни и проверить готовность больниц
В одном из районов Монголии зафиксирован случай заражения человека чумой. По официальной информации, он съел мясо зараженного суслика. Российская санитарная служба сразу же отреагировала и призвала усилить профилактику в местах, где возможны чумные очаги. Об этом говорится в постановлении главного государственного санитарного врача, которое вступает в силу 4 июля.
Барьер в 500 километров
В конце июня в Монголии у 21-летнего парня выявили чуму. Как сообщили в Национальном центре зоонозных инфекций, это случилось из-за употребления в пищу инфицированного мяса суслика. Монгольские специалисты сразу приняли меры, чтобы инфекция не распространялась. Юношу положили в больницу, а сорок человек, которые с ним контактировали, срочно изолировали.
Как заверили «Парламентскую газету» в Роспотребнадзоре, россиянам бояться заражения чумой не нужно. «Территория, где зафиксировали случай заболевания, граничит с Китаем и находится на расстоянии более 500 километров от российской границы. Поэтому риск завоза оттуда заболевания исключен», — пояснили в пресс-службе ведомства.
Постоянный мониторинг
Сейчас риска распространения чумы на территории России нет, заверил наше издание и академик РАН, экс-глава Роспотребнадзора Геннадий Онищенко: «У нас налажена системная работа. На границе с Монголией три противочумные станции мониторят природные очаги. После появления заявлений о заражении человека чумой регион курирует Иркутский противочумный институт во главе с профессором Балахоновым. Ведется постоянное наблюдение. Более того, Балахонов на прошлой неделе был в Монголии по этому поводу. Ситуацию держат под контролем. Что касается опасных мест, которые есть в нашей стране, прежде всего Горный Алтай, там в преддверии сезона привили весь Кош-Агачский район, это примерно 18 тысяч человек».
В высокогорном Кош-Агачском районе расположен природный очаг чумы. Впервые его обнаружили в 1961 году, когда в долине реки Уландрык от грызунов и блох выделили десять штаммов чумного микроба. Наблюдение в этом районе идет постоянно. Последний единичный случай заболевания человека чумой здесь был в 2016 году — заразился непривитый ребенок, участвовавший в разделке сурка. Вакцинацию в районе проводят каждую весну.
Читайте также:
• Россельхознадзор не пустит в Россию американских клопов
Профилактики много не бывает
Чтобы к опасности появления чумы так же внимательно относились в каждом регионе, в Роспотребнадзоре подготовили постановление, в котором призвали усилить профилактику. «Документ разработали для уменьшения опасности завоза чумы на территорию России и чтобы исключить возможность распространения этой болезни», — пояснили в пресс-службе.
Так, в постановлении рекомендовали властям проинформировать людей о способах профилактики чумы, определить категории граждан, которых нужно обязательно привить от этой болезни. Особенно это актуально для районов, где есть природные очаги заразы, к примеру Горно-Алтайска, Забайкалья, Дагестана.
Кроме того, в документе указали ежегодные поручения, которые нужно выполнять до 1 июня. Например, проверить готовность инфекционных больниц к противоэпидемическим мероприятиям, если выявят больного с подозрением на чуму. В клиниках должно хватать средств индивидуальной защиты и дезинфекции, лечебных и диагностических препаратов, говорится в постановлении.
До начала лета каждый год нужно теоретически и практически подковать различных специалистов в вопросах профилактики чумы и проведения противоэпидемических мероприятий. Важно, чтобы медики, в том числе и те, кто трудится в скорой помощи, сотрудники лабораторий, патолого-анатомических отделений, эпидемиологи, специалисты санитарно-карантинных и контрольно-пропускных пунктов с повышенной настороженностью относились к возможному появлению чумы у людей. Они должны быть готовы к проведению исследований и экспресс-тестов.
 10037
10037
Ещё материалы: Геннадий Онищенко









